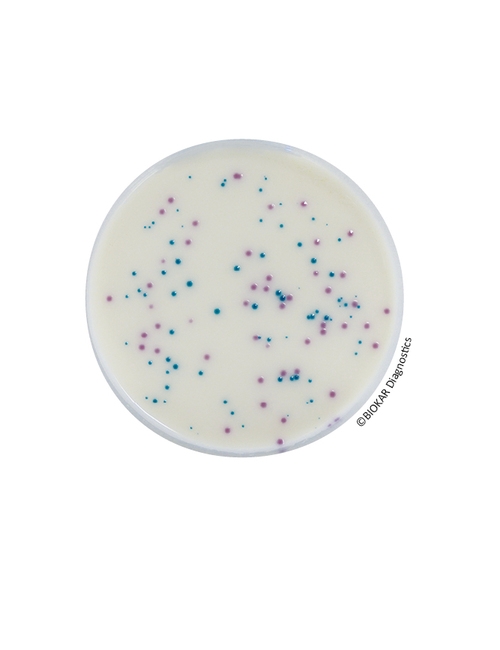
img

IRIS SALMONELLA®
IRIS Salmonella®
Kromojenik (Chromogenic) Salmonella Agar
İnsani tüketim amaçlı gıdalarda, hayvan yemlerinde ve çevresel örneklerde Salmonella türlerinin tespiti için alternatif,rapid, koromojenik ve AFNOR tarafından valide edilmiş bir yöntemdir. (Validasyon referans numarası BKR 23 / 07-10 / 11).
IRIS Salmonella®;
- 25g ve daha büyük miktardaki örneklerde
- Tüm gıda, yem ve çevresel numunelerin analizinde kullanılabilir.
IRIS Salmonella® şüpheli ve sekonder kolonilerin berrak agar yüzeyine mükemmel kontrast sağlayacak şekilde gelişmesine imkan veren özel bir bileşimi sahiptir.
Performans
- Hareketli/hareketsiz, tipik/atipik tüm Salmonella türlerinin tespitini sağlar.
Seçicilik
- ISO 6579 standardında tavsiye edilen ikinci seçici katı besiyeri listesinde yer almakatadır.
Kolay - Hızlı
- 37 saatte
- Bütün Salmonella spp.'lerin pembe-eflatun pembe
- Sekonder floranın ise mavi-lacivert
Basit - Ekonomik
- Yalnızca 2 basamakta
- Seçici zenginleştirme
- Seçici katı agarda izolasyon
Güvenilier
- ISO 6579 standardı referans alınarak 16140 alternatif metot validasyon standardı kapsamında AFNOR tarafından BKR 23 / 07-10 / 11 referans numarası ile valide edilmiştir. bir yöntem olan
IRIS Salmonella® Agar, tipik/atipik türler ve serotipleri dahil Salmonella spp.'nin saptanması için yüksek seçiciliğie sahiptir. Salmonella Typhi ve Paratyphi, laktoz pozitif Salmonellae (Salmonella senftenberg ve alt türler S. arizonae ve S. diarizonae), sakkaroz pozitif suşların saptanmasını sağlar. Ayrıca, hareketsiz serotiplerin (S. Pullorum ve S. Gallinarum) veya monofazik suşların saptanmasına da olanak verir.
IRIS Salmonella® Agar, (Salmonella bongori, Salmonella dublin ve atento, bazı S. enterica suşları, S. houtenae ve S. diarizonae alt türleri) esterasik aktivitenin varlığını ya da yokluğunu gösteren suşların saptanmasına da imkan verir.

Ürün Adı: IRIS Salmonella® - Latex agglutination kit
Ürün Kodu: BT01108
Miktar: Kit of 50 Test

Ürün Adı: IRIS Salmonella® Supplement - Tablets qsp 90 ml
Ürün Kodu: BS09308
Miktar: 120 tablets qsp 90 mL

Ürün Adı: IRIS Salmonella® Supplement - Tablets qsp 225 ml
Ürün Kodu: BS07708
Miktar: 120 tablets qsp 225 mL

Ürün Adı: IRIS Salmonella® Supplement liquid
Ürün Kodu: BS07808
Miktar: 10 şişe x 50 mL

Ürün Adı: IRIS Salmonella® Enrichment Broth W Tween® 80 (BPW)
Ürün Kodu: BM16308
Miktar: 3 flexible bags of 3 L

Ürün Adı: Salmonella® Enrichment Broth (BPW)
Ürün Kodu: BM14408
Miktar: 2 flexible bags of 5 L

Ürün Adı: Salmonella® Enrichment Broth (BPW)
Ürün Kodu: BM13708
Miktar: 3 flexible bags of 3 L

Ürün Adı: Salmonella® Enrichment Broth (BPW)
Ürün Kodu: BM13608
Miktar: 10 şişe x 225 mL

Ürün Adı: Salmonella Enrichment Broth (BPW)
Ürün Kodu: BK194GC
Miktar: 5 kg

Ürün Adı: Salmonella Enrichment Broth (BPW)
Ürün Kodu: BK194HA
Miktar: 500 g

Ürün Adı: IRIS Salmonella® Agar
Ürün Kodu: BK212HA
Miktar: 500 g

Ürün Adı: IRIS Salmonella® Agar (RTU)
Ürün Kodu: BM16108
Miktar: 120 Petri plates Ø 90 mm
Ürün Adı: IRIS Salmonella® Agar (RTU)
Ürün Kodu: BM16008
Miktar: 20 Petri plates Ø 90 mm
TECHNICAL DATA SHEET
TDS_IRIS SALMONELLA_BM160_161_BS077_078_ENv4
MSDS
Non classification statement_BM160_161
FDS_MSDS_BK212_v1
Non classification statement_BM136_137_144
Non classification statement_BM163
Non classification statement_BK194
FDS_MSDS_BS077_v2
FDS_MSDS_BS078_v1
FDS_MSDS_BS093_v2
Non classification statement_BT011_R1_R2
